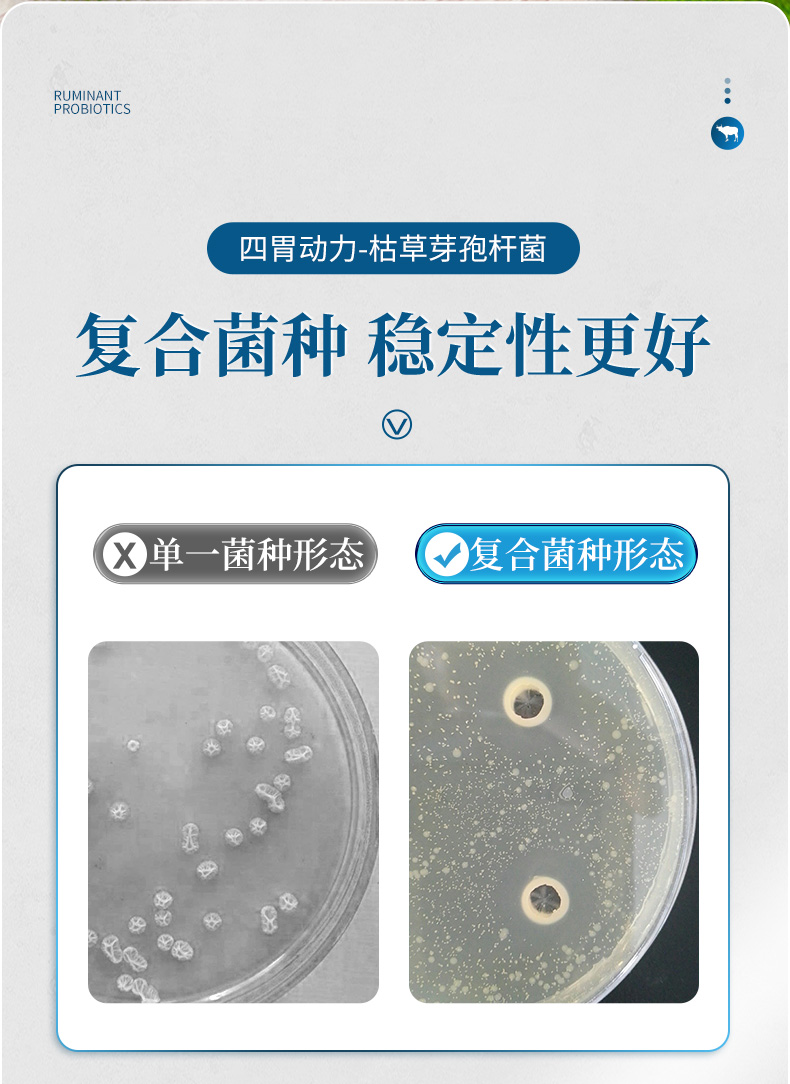

【积分兑换】华畜四胃动力500ml 提高肠胃消化力改善胃积食
¥6.97
-
华畜官方微信旗舰店
(微信公众号认证)
- 扫描二维码,访问我们的微信店铺
- 随时随地的购物、客服咨询、查询订单和物流...
【积分兑换】华畜四胃动力500ml 提高肠胃消化力改善胃积食
1. 打开微信,扫一扫左侧二维码
2. 点击右上角图标

3. 发送给朋友、分享到朋友圈、收藏

打开微信,扫一扫
或搜索微信号:wsw465841162
1. 打开微信,扫一扫左侧二维码
2. 点击右上角图标

3. 发送给朋友、分享到朋友圈、收藏